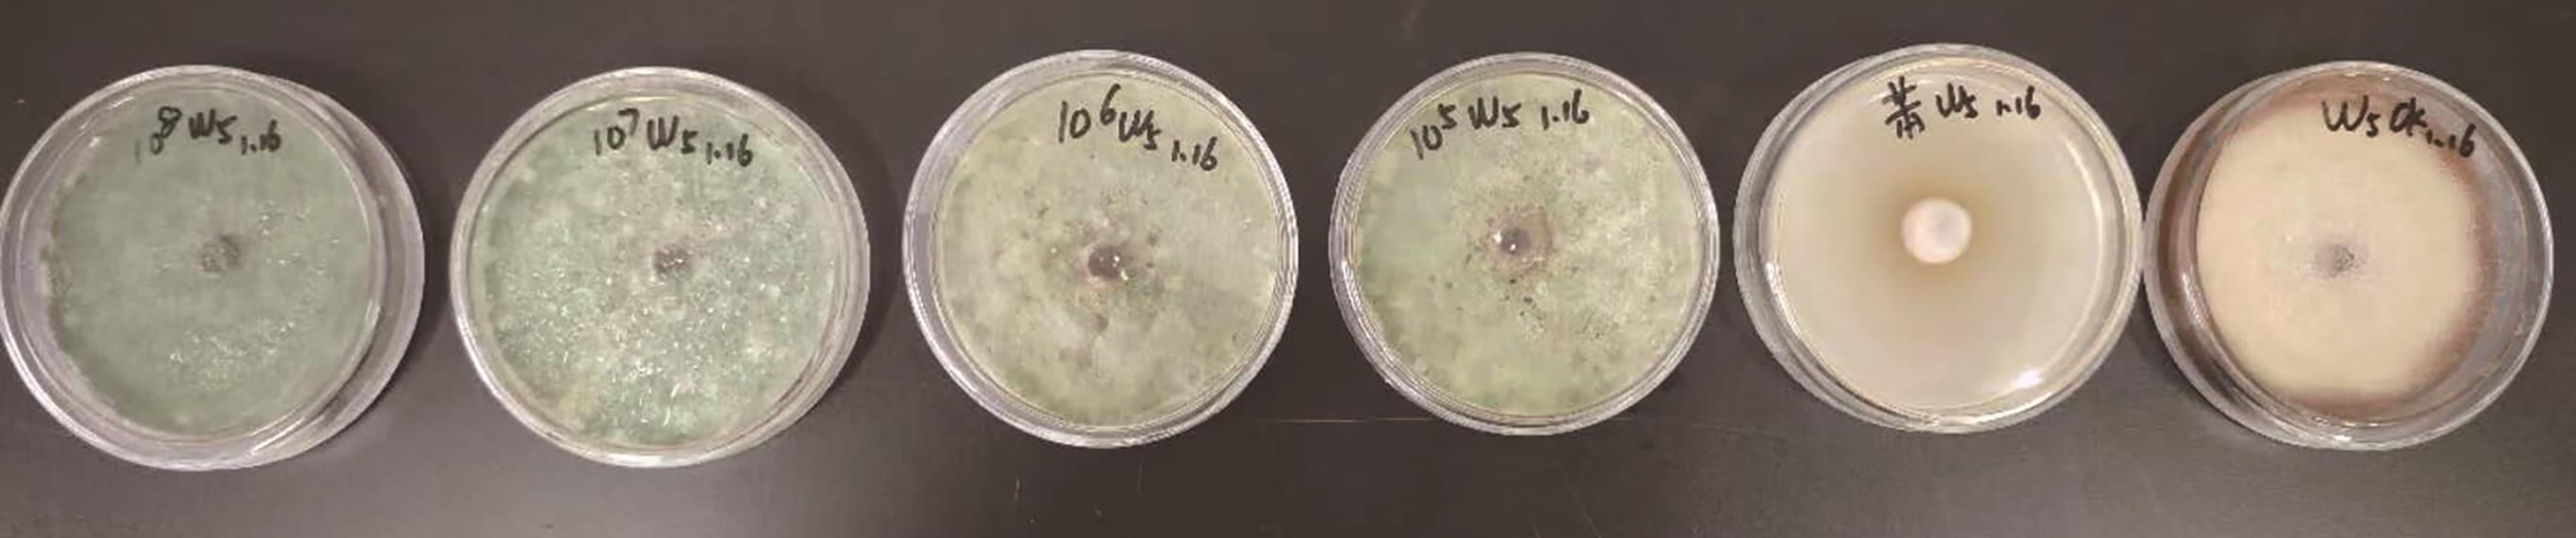

Biotechnology Bulletin ›› 2025, Vol. 41 ›› Issue (9): 277-288.doi: 10.13560/j.cnki.biotech.bull.1985.2025-0306
SU Xiu-min1( ), HAN Wen-qing1(
), HAN Wen-qing1( ), WANG Jiao1(
), WANG Jiao1( ), LI Peng2, WANG Qiu-lan1, LI Wan-xing1(
), LI Peng2, WANG Qiu-lan1, LI Wan-xing1( ), CAO Jin-jun1
), CAO Jin-jun1
Received:2025-03-21
Online:2025-09-26
Published:2025-09-24
Contact:
WANG Jiao, LI Wan-xing
E-mail:suxiumin123@163.com;wj_x87@126.com;gzslwx@163.com
SU Xiu-min, HAN Wen-qing, WANG Jiao, LI Peng, WANG Qiu-lan, LI Wan-xing, CAO Jin-jun. Isolation, Identification, Biological Characteristics and Biocontrol Effects of Trichoderma harzianum M408 against Tomato Early Blight[J]. Biotechnology Bulletin, 2025, 41(9): 277-288.

Fig. 4 Effects of carbon source, temperature, light type and pH on mycelial growth and sporulation of strain T. harzianum M408Different lowercase letters in the figure indicate significant differences (P<0.05), the same below
药剂 Agent | 浓度 Concentration | 抑制率 Inhibition (%) |
|---|---|---|
M408原菌粉菌剂 M408 strain original spore powder agent | 108 CFU/mL | 100±0a |
| 107 CFU/mL | 100±0a | |
| 106 CFU/mL | 98.51±0b | |
| 105 CFU/mL | 93.43±0.365c | |
325 g/L苯甲·醚菌酯悬浮剂 325 g/L difenoconazole azoxystrobin SC | 1.0 g/L | 89.55±0d |
| 清水 Water | 0 | --- |
Table 1 Inhibition rates of T. harzianum M408 strain original spore powder agent on A. solani (W5) (7 d)
药剂 Agent | 浓度 Concentration | 抑制率 Inhibition (%) |
|---|---|---|
M408原菌粉菌剂 M408 strain original spore powder agent | 108 CFU/mL | 100±0a |
| 107 CFU/mL | 100±0a | |
| 106 CFU/mL | 98.51±0b | |
| 105 CFU/mL | 93.43±0.365c | |
325 g/L苯甲·醚菌酯悬浮剂 325 g/L difenoconazole azoxystrobin SC | 1.0 g/L | 89.55±0d |
| 清水 Water | 0 | --- |
Fig. 6 Inhibitory effects of T. harzianum M408 original spore powder agent on Alternaria solani (W5) (7 d)From left to right, spore concentration are 108, 107, 106, and 105 CFU/mL T. harzianum M408 original spore powder agent, 1.0 g/L of 325 g/L difenoconazole azoxystrobin SC, blank CK
药剂 Agent | 浓度 Concentration | 药前病情指数 Disease index before application | 第一次药后7 d 7 d after the first application | 第二次药后7 d 7 d after the second application | |||
|---|---|---|---|---|---|---|---|
病情指数 Disease index | 相对防效 Relative prevention effect (%) | 病情指数 Disease index | 相对防效 Relative prevention effect (%) | ||||
M408原菌粉菌剂 M408 strain original spore powder agent | 108 CFU/mL | 1.19 | 0.87 | 87.30±2.01a | 2.07 | 89.44±0.55a | |
| 107 CFU/mL | 1.33 | 1.15 | 85.57±1.64ab | 2.85 | 87.07±0.93ab | ||
| 106 CFU/mL | 1.37 | 1.42 | 82.51±1.30ab | 3.48 | 84.56±1.00b | ||
| 105 CFU/mL | 1.22 | 1.48 | 79.71±2.75bc | 3.85 | 81.01±0.67c | ||
325 g/L苯甲·醚菌酯悬浮剂 325 g/L Difenoconazole azoxystrobin SC | 1.0 g/L | 1.26 | 1.87 | 75.63±1.86c | 4.93 | 76.37±1.98d | |
| 清水 Water | 0 | 1.33 | 8.01 | -- | 27.59 | -- | |
Table 2 Field control effect of M408 strain original spore powder agent on tomato early blight
药剂 Agent | 浓度 Concentration | 药前病情指数 Disease index before application | 第一次药后7 d 7 d after the first application | 第二次药后7 d 7 d after the second application | |||
|---|---|---|---|---|---|---|---|
病情指数 Disease index | 相对防效 Relative prevention effect (%) | 病情指数 Disease index | 相对防效 Relative prevention effect (%) | ||||
M408原菌粉菌剂 M408 strain original spore powder agent | 108 CFU/mL | 1.19 | 0.87 | 87.30±2.01a | 2.07 | 89.44±0.55a | |
| 107 CFU/mL | 1.33 | 1.15 | 85.57±1.64ab | 2.85 | 87.07±0.93ab | ||
| 106 CFU/mL | 1.37 | 1.42 | 82.51±1.30ab | 3.48 | 84.56±1.00b | ||
| 105 CFU/mL | 1.22 | 1.48 | 79.71±2.75bc | 3.85 | 81.01±0.67c | ||
325 g/L苯甲·醚菌酯悬浮剂 325 g/L Difenoconazole azoxystrobin SC | 1.0 g/L | 1.26 | 1.87 | 75.63±1.86c | 4.93 | 76.37±1.98d | |
| 清水 Water | 0 | 1.33 | 8.01 | -- | 27.59 | -- | |
| [1] | Grigolli JFJ, Kubota MM, Alves DP, et al. Characterization of tomato accessions for resistance to early blight [J]. Crop Breed Appl Biotechnol, 2011, 11(2): 174-180. |
| [2] | Fry WE, Birch PJ, Judelson HS, et al. Five reasons to consider Phytophthora infestans a reemerging pathogen [J]. Phytopathology, 2015, 105(7): 966-981. |
| [3] | Ji JY, Yang J, Zhang BW, et al. Sodium pheophorbide a controls cherry tomato gray mold (Botrytis cinerea) by destroying fungal cell structure and enhancing disease resistance-related enzyme activities in fruit [J]. Pestic Biochem Physiol, 2020, 166: 104581. |
| [4] | 李丙雪, SIHOMCHANH Bounpheng, 禤子琪, 等. 番茄枯萎病防治药剂的筛选 [J]. 中国瓜菜, 2021, 34(2): 61-64. |
| Li BX, Bounpheng SC, Xuan ZQ, et al. Screening of fungicides on Fusarium wilt of tomato [J]. China Cucurbits and Vegetables, 2021, 34( 2) : 61-64. | |
| [5] | 赵文珺, 葛蓓孛, 刘炳花, 等. 甲基营养型芽胞杆菌NKG-1对番茄白粉病的防病促生作用研究 [J]. 中国农学通报, 2018, 34(23): 104-109. |
| Zhao WJ, Ge BB, Liu BH, et al. Bacillus methylotrophicus strain NKG-1: growth promotion and disease control effect on tomato powdery mildew [J]. Chin Agric Sci Bull, 2018, 34(23): 104-109. | |
| [6] | Rasool M, Akhter A, Soja G, et al. Role of biochar, compost and plant growth promoting rhizobacteria in the management of tomato early blight disease [J]. Sci Rep, 2021, 11(1): 6092. |
| [7] | 葛晓颖, 孙志刚, 李涛, 等. 设施番茄连作障碍与土壤芽孢杆菌和假单胞菌及微生物群落的关系分析 [J]. 农业环境科学学报, 2016, 35(3): 514-523. |
| Ge XY, Sun ZG, Li T, et al. Soil Pseudomonas spp., Bacillus spp., and microbial communities under tomato continuous cropping in greenhouse production [J]. J Agro Environ Sci, 2016, 35(3): 514-523. | |
| [8] | Huang CJ, Wang TK, Chung SC, et al. Identification of an antifungal chitinase from a potential biocontrol agent, Bacillus cereus 28-9 [J]. J Biochem Mol Biol, 2005, 38(1): 82-88. |
| [9] | 孟素玲, 田彦梅, 顾欣, 等. 木霉的协同防病作用研究进展 [J]. 中国生物防治学报, 2022, 38(3): 739-747. |
| Meng SL, Tian YM, Gu X, et al. Research progress on synergistic disease prevention by Trichoderma [J]. Chin J Biol Control, 2022, 38(3): 739-747. | |
| [10] | 翟明娟, 李登辉, 马玉琴, 等. 绿色木霉菌株Tvir-6对黄瓜根结线虫的防治效果研究 [J]. 中国蔬菜, 2017(10): 67-72. |
| Zhai MJ, Li DH, Ma YQ, et al. Studies on biocontrol effect of Trichoderma viride tvir-6 against root knot nematode on cucumber [J]. China Veg, 2017(10): 67-72. | |
| [11] | 陈云云, 李慧霞, 张海英, 等. 萎缩芽胞杆菌 MQ19ST15 鉴定及对甘蓝枯萎病的盆栽防效 [J]. 植物保护, 2021, 47 (5) : 64 -71. |
| Chen YY, Li HX, Zhang HY, et al. Identification of Bacillus ataophaeus MQ19ST15 and its control efficacy against Fusarium wilt on potted cabbage plants [J]. Pant Protection, 2021, 47(5): 64-71. | |
| [12] | 徐艳辉, 李烨, 许向阳. 番茄枯萎病的研究进展 [J]. 东北农业大学学报, 2008, 39(11): 128-134. |
| Xu YH, Li Y, Xu XY. Progress in research on Fusarium wilt of tomato [J]. J Northeast Agric Univ, 2008, 39(11): 128-134. | |
| [13] | 李梅, 田莹, 蒋细良. 植物内生木霉菌研究进展 [J]. 中国生物防治学报, 2020, 36(2): 155-162. |
| Li M, Tian Y, Jiang XL. Advances in research on endophytic Trichoderma in plants [J]. Chin J Biol Control, 2020, 36(2): 155-162. | |
| [14] | Druzhinina IS, Seidl-Seiboth V, Herrera-Estrella A, et al. Trichoderma: the genomics of opportunistic success [J]. Nat Rev Microbiol, 2011, 9(10): 749-759. |
| [15] | 张广志, 张新建, 陈泉, 等. 哈茨木霉复合种内3个中国新记录种的分离和鉴定 [J]. 山东科学, 2015, 28(6): 43-46, 51. |
| Zhang GZ, Zhang XJ, Chen Q, et al. Isolation and identification of three Chinese new records in Trichoderma harzianum species complex [J]. Shandong Sci, 2015, 28(6): 43-46, 51. | |
| [16] | 尤佳琪, 吴明德, 李国庆. 木霉在植物病害生物防治中的应用及作用机制 [J]. 中国生物防治学报, 2019, 35(6): 966-976. |
| You JQ, Wu MD, Li GQ. Application and mechanism of Trichoderma in biological control of plant disease [J]. Chin J Biol Control, 2019, 35(6): 966-976. | |
| [17] | 潘亚妮, 惠有为. 绿色木霉防治温室灰霉病研究 [J]. 安徽农业科学, 2010, 38(15): 7913-7914, 7964. |
| Pan YN, Hui YW. Study on Trichoderma viride strains to control vegetable grey mould in greenhouse [J]. J Anhui Agric Sci, 2010, 38(15): 7913-7914, 7964. | |
| [18] | 危潇, 黎妍妍, 姚经武, 等. 哈茨木霉WF2 菌株鉴定及对烟草黑胫病的防效 [J]. 中南农业科技, 2023, 44(11): 12-15. |
| Wei X, Li YY, Yao JW, et al. Identification of Trichoderma harzianum WF2 strain and its control effect on tobacco black shank [J]. South-Central Agricultural Science and Technology, 2023, 44(11): 12-15. | |
| [19] | 原甜甜, 李宗阳, 陈佳佳, 等. 核桃炭疽病新型生防木霉的筛选及生物学特性研究 [J]. 林产工业, 2023, 60(6): 57-63. |
| Yuan TT, Li ZY, Chen JJ, et al. Selecting and biological characteristics of Trichoderma sp. against walnut anthracnose [J]. China Forest Products Industry, 2023, 60(6): 57-63. | |
| [20] | Rojo FG, Reynoso MM, Ferez M, et al. Biological control by Trichoderma species of Fusarium solani causing peanut brown root rot under field conditions [J]. Crop Prot, 2007, 26(4): 549-555. |
| [21] | 王永阳, 杜佳, 高克祥. 苦瓜枯萎病生防木霉的筛选鉴定及其定殖的qPCR检测 [J]. 山东农业科学, 2018, 50(8) : 110-115. |
| Wang YY, Du J, Gao KX. Screening and identification of biocontrol Trichoderma to wilt of bitter gourd and detection of its colonization by qPCR [J]. Shandong Agricultural Sciences, 2018, 50(8): 110-115. | |
| [22] | 吕黎, 许丽媛, 罗志威, 等. 哈茨木霉生物防治研究进展 [J]. 湖南农业科学, 2013(17): 92-95. |
| Lv L, Xu LY, Luo ZW, et al. Research progress of biocontrol effect of Trichoderma harzianum [J]. Hunan Agric Sci, 2013(17): 92-95. | |
| [23] | 王桂清, 曾路, 马迪, 等. 我国近10年植物致病真菌生物学特性研究综述 [J]. 江苏农业科学, 2018, 46(19): 1-5. |
| Wang GQ, Zeng L, Ma D, et al. Study on biological characteristics of plant pathogenic fungi in China in recent 10 years: a review [J]. Jiangsu Agric Sci, 2018, 46(19): 1-5. | |
| [24] | Bissett J, Gams W, Jaklitsch W, et al. Accepted Trichoderma names in the year 2015 [J]. IMA Fungus, 2015, 6(2): 263-295. |
| [25] | Verma M, Brar SK, Tyagi RD, et al. Antagonistic fungi, Trichoderma spp. panoply of biological control [J]. Biochem Eng J, 2007, 37(1): 1-20. |
| [26] | Harman GE. Myths and dogmas of biocontrol changes in perceptions derived from research on Trichoderma harzinum T-22 [J]. Plant Dis, 2000, 84(4): 377-393. |
| [27] | 尤佳琪, 杜然, 顾卫红, 等. 拟康宁木霉T-51菌株生物学特性及其生物防治潜力 [J]. 植物保护学报, 2022, 49(3): 946-955. |
| You JQ, Du R, Gu WH, et al. Biological characteristics and biological control potential of endophytic fungus Trichoderma koningiopsis strain T-51 [J]. J Plant Prot, 2022, 49(3): 946-955. | |
| [28] | Prather TS, Lanini WT, Orloff S, et al. Interplanting grasses into alfalfa controls weeds in older stands [J]. Cal Ag, 2000, 54(6): 37-41. |
| [29] | 杨合同. 木霉分类与鉴定 [M]. 北京: 中国大地出版社, 2009. |
| Yang HT. Classification and identification of Trichoderma [M]. Beijing: China Land Press, 2009. | |
| [30] | 田淼, 彭玉飞, 吕红, 等. 非洲哈茨木霉LMNS-M9的鉴定、生物学特性及其对藜麦的促生作用 [J]. 微生物学通报, 2023, 50(9): 3848-3865. |
| Tian M, Peng YF, Lü H, et al. Trichoderma afroharzianum LMNS-M9: identification, biological characteristics, and growth-promoting effect on quinoa [J]. Microbiol China, 2023, 50(9): 3848-3865. | |
| [31] | Bell DK. In vitro antagonism ofTrichodermaspecies against six fungal plant pathogens [J]. Phytopathology, 1982, 72(4): 379. |
| [32] | 田桢, 曹传旺, 季世达, 等. 新疆野果林木霉分离鉴定、抑菌作用及固态发酵配方优化 [J]. 微生物学通报, 2021, 48(12): 4696-4709. |
| Tian Z, Cao CW, Ji SD, et al. Isolation and identification of Trichoderma strains, and antifungal effects and solid-state fermentation recipe optimization from Xinjiang wild fruit forest [J]. Microbiol China, 2021, 48(12): 4696-4709. | |
| [33] | 李万星, 李丹, 李小霞, 等. 不同轮作模式对旱地番茄品质、产量及土壤真菌多样性的影响 [J]. 华北农学报, 2022, 37(4): 82-89. |
| Li WX, Li D, Li XX, et al. Effects of different rotation patterns on tomato quality and yield and soil fungi diversity in dryland [J]. Acta Agriculturae Boreali-Sinica, 2022, 37(4): 82-89. | |
| [34] | 罗洋, 滕应, 罗绪强, 等. 里氏木霉FS10-C可湿性粉剂的研制及其促生效果测定 [J]. 生物技术通报, 2016, 32(8): 194-199. |
| Luo Y, Teng Y, Luo XQ, et al. Development of wettable powder of Trichoderma reesei FS10-C and its plant growth-promoting effects [J]. Biotechnol Bull, 2016, 32(8): 194-199. | |
| [35] | 邓龙, 邓勋, 尹大川, 等. 木霉菌株TC-14的生物学特性及rDNA ITS序列测定 [J]. 黑龙江生态工程职业学院学报, 2012, 25(5): 23-25. |
| Deng L, Deng X, Yin DC, et al. Biological characteristics and rDNA ITS sequencing of Trichoderma isolate TC-14 [J]. Journal of Heilongjiang Vocational Institute of Ecological Engineering, 2012, 25(5): 23-25. | |
| [36] | 佟昀铮, 于汇琳, 潘洪玉, 等. 玉米茎腐病生防菌哈茨木霉CCTH-2鉴定及其生物学特性 [J]. 华北农学报, 2022, 37(S1): 309-317. |
| Tong YZ, Yu HL, Pan HY, et al. Identification of Trichoderma harzianum CCTH-2 and its biological characteristics, a biocontrol fungi against corn stalk rot [J]. Acta Agriculturae Boreali-Simica, 2022, 37 (S1): 309-317. | |
| [37] | 梁松, 魏甜甜, 张静蕾, 等. 辣椒枯萎病生防木霉菌 T21 的分离鉴定及其生物学特性研究 [J]. 天津农业科学, 2022, 28(5): 59-66. |
| Liang S, Wei TT, Zhang JL, et al. Isolation, identification, control effect and biological characteristics of Trichoderma biocontrol of pepper Fusarium wilt [J]. Tianjin Agricultural Sciences, 2022, 28(5): 59-66. | |
| [38] | 李梅云, 谭丽华, 方敦煌, 等. 哈茨木霉的培养及其对烟草疫霉生长的抑制研究 [J]. 微生物学通报, 2006, 33(6): 79-83. |
| Li MY, Tan LH, Fang DH, et al. Cultural characteristics of Trichoderma harzianum and its inhibition to Phytophthora nicotianae [J]. Microbiology, 2006, 33(6): 79-83. | |
| [39] | 赵晓彤, 王桂清. 不同培养条件对长枝木霉 SMF2 和哈茨木霉 T39生长与产孢的影响 [J]. 山东农业科学, 2023, 55(8): 56-64. |
| Zhao XT, Wang GQ. Effects of Different Culture Conditions on Growth and Sporulation of Trichoderma Longibrachiatum SMF2 and Trichoderma Harzianum T39 [J]. Shandong Agricultural Sciences, 2023, 55(8): 56-64. | |
| [40] | Chowdappa P, Mohan Kumar SP, Jyothi Lakshmi M, et al. Growth stimulation and induction of systemic resistance in tomato against early and late blight by Bacillus subtilis OTPB1 or Trichoderma harzianum OTPB3 [J]. Biol Control, 2013, 65(1): 109-117. |
| [41] | Fontenelle ADB, Guzzo SD, Lucon CMM, et al. Growth promotion and induction of resistance in tomato plant against Xanthomonas euvesicatoria and Alternaria solani by Trichoderma spp [J]. Crop Prot, 2011, 30(11): 1492-1500. |
| [42] | Marzano M, Gallo A, Altomare C. Improvement of biocontrol efficacy of Trichoderma harzianum vs. Fusarium oxysporum f. sp. lycopersici through UV-induced tolerance to fusaric acid [J]. Biol Control, 2013, 67(3): 397-408. |
| [43] | Malmierca MG, Barua J, McCormick SP, et al. Novel aspinolide production by Trichoderma arundinaceum with a potential role in Botrytis cinerea antagonistic activity and plant defence priming [J]. Environ Microbiol, 2015, 17(4): 1103-1118. |
| [44] | Contreras-Cornejo HA, Macías-Rodríguez L, Herrera-Estrella A, et al. The 4-phosphopantetheinyl transferase of Trichoderma virens plays a role in plant protection against Botrytis cinerea through volatile organic compound emission [J]. Plant Soil, 2014, 379(1): 261-274. |
| [45] | 张晓尘, 张红杰, 李生兵, 等. 哈茨木霉EMF910对宁夏盐碱地区黄芪根腐病致病菌的防治作用 [J]. 微生物学通报, 2024, 51(10): 4162-4180. |
| Zhang XC, Zhang HJ, Li SB, et al. The control effect of Trichoderma harzianum EMF910 on the root rot pathogens of Astragalus membranaceus in Ningxia saline-alkali regions [J]. Microbiol China, 2024, 51(10): 4162-4180. | |
| [46] | 陈凯, 隋丽娜, 赵忠娟, 等. 木霉共培养发酵对黄瓜枯萎病的防治效果 [J]. 中国生物防治学报, 2022, 38(1): 108-114. |
| Chen K, Sui LN, Zhao ZJ, et al. Control effect of co-cultured fermentation of two Trichoderma strains on cucumber Fusarium wilt [J]. Chin J Biol Control, 2022, 38(1): 108-114. | |
| [47] | Reino JL, Guerrero RF, Hernández-Galán R, et al. Secondary metabolites from species of the biocontrol agent Trichoderma [J]. Phytochem Rev, 2008, 7(1): 89-123. |
| [48] | Deacon JW, Berry LA. Modes of action of mycoparasites in relation to biocontrol of soilborne plant pathogens [M]//Biological Control of Plant Diseases. Boston, MA: Springer US, 1992: 157-167. |
| [49] | 陆洪省, 张雪, 高宇婷, 等. 哈茨木霉SKD-ZX-1的鉴定、发酵及其生防效果 [J]. 生物技术通报, 2019, 35(11): 132-140. |
| Lu HS, Zhang X, Gao YT, et al. Identification, fermentation and biocontrol efficiency of Trichoderma harzianum SKD-ZX-1 [J]. Biotechnol Bull, 2019, 35(11): 132-140. | |
| [50] | 曲薇, 伍淼, 王旭东, 等. 哈茨木霉菌株WY-1对番茄的促生防病效果 [J]. 江苏农业科学, 2018, 46(5): 94-96. |
| Qu W, Wu M, Wang XD, et al. Effects of Trichoderma harzianum strain WY-1 on growth and disease control of tomato [J]. Jiangsu Agric Sci, 2018, 46(5): 94-96. |
| [1] | ZHANG Ru, LI Yi-ming, ZHANG Tong-xi, SUN Zhan-bin, REN Qing, PAN Han-xu. Isolation and Identification of a High-yielding Magnolol and Honokiol Strain from Magnolia officinalis and Optimization of the “Sweating” Process [J]. Biotechnology Bulletin, 2025, 41(8): 322-334. |
| [2] | XIANG Bo-ka, ZHOU Zuan-zuan, FENG Jia-hui, XIA Chen, LI Qi, CHEN Chun. Isolation and Identification of a Fungus from Moldy Tobacco Leaf and Study on Its Mold-causing Factors [J]. Biotechnology Bulletin, 2025, 41(2): 321-330. |
| [3] | ZHANG Ya-ya, LI Pan-pan, GAO Hui-hui, JIA Chen-bo, XU Chun-yan. Exploring on the Pathogenesis of Root Rot of Lycium barbarum cv. ‘Ningqi-5' Based on the Rhizoplane Fungal Community and Pathogens Identification [J]. Biotechnology Bulletin, 2024, 40(9): 238-248. |
| [4] | WANG Fang, YU Lu, QI Ze-zheng, ZHOU Chang-jun, YU Ji-dong. Screening and Biocontrol Effect of Antagonistic Bacteria against Soybean Root Rot [J]. Biotechnology Bulletin, 2024, 40(7): 216-225. |
| [5] | RAO Yong-bin, ZHANG Jun-li. Biological Characteristics, Domestication and Cultivation of Wild Gymnopilus subpurpuratus [J]. Biotechnology Bulletin, 2024, 40(4): 264-270. |
| [6] | WANG Lu, LIU Meng-yu, ZHANG Fu-yuan, JI Shou-kun, WANG Yun, ZHANG Ying-jie, DUAN Chun-hui, LIU Yue-qin, YAN Hui. Isolation and Identification of Rumen Skatole-degrading Bacteria and Analysis on Their Degradation Characteristics [J]. Biotechnology Bulletin, 2024, 40(3): 305-311. |
| [7] | RAO Zi-huan, XIE Zhi-xiong. Isolation and Identification of a Cellulose-degrading Strain of Olivibacter jilunii and Analysis of Its Degradability [J]. Biotechnology Bulletin, 2023, 39(8): 283-290. |
| [8] | YOU Zi-juan, CHEN Han-lin, DENG Fu-cai. Research Progress in the Extraction and Functional Activities of Bioactive Peptides from Fish Skin [J]. Biotechnology Bulletin, 2023, 39(7): 91-104. |
| [9] | CHE Yong-mei, GUO Yan-ping, LIU Guang-chao, YE Qing, LI Ya-hua, ZHAO Fang-gui, LIU Xin. Isolation and Identification of Bacterial Strain C8 and B4 and Their Halotolerant Growth-promoting Effects and Mechanisms [J]. Biotechnology Bulletin, 2023, 39(5): 276-285. |
| [10] | WANG Feng-ting, WANG Yan, SUN Ying, CUI Wen-jing, QIAO Kai-bin, PAN Hong-yu, LIU Jin-liang. Isolation and Identification of Saline-alkali Tolerant Aspergillus terreus SYAT-1 and Its Activities Against Plant Pathogenic Fungi [J]. Biotechnology Bulletin, 2023, 39(2): 203-210. |
| [11] | LI Ying, SONG Xin-ying, HE Kang, GUO Zhi-qing, YU Jing, ZHANG Xia. Isolation and Identification of Bacillus velezensis ZHX-7 and Its Antibacterial and Growth-promoting Effects [J]. Biotechnology Bulletin, 2023, 39(12): 229-236. |
| [12] | DONG Yi-hua, WANG Ling-xiao, REN Han-xue, CHEN Feng. Isolation and Identification of a Psychrotolerant Heterotrophic Nitrification-aerobic Denitrification Bacterium and Its Nitrogen-removing Characteristics [J]. Biotechnology Bulletin, 2023, 39(12): 237-249. |
| [13] | WEN Chang, LIU Chen, LU Shi-yun, XU Zhong-bing, AI Chao-fan, LIAO Han-peng, ZHOU Shun-gui. Biological Characteristics and Genome Analysis of a Novel Multidrug-resistant Shigella flexneri Phage [J]. Biotechnology Bulletin, 2022, 38(9): 127-135. |
| [14] | ZU Xue, ZHOU Hu, ZHU Hua-jun, REN Zuo-hua, LIU Er-ming. Isolation and Identification of Bacillus subtilis K-268 and Its Biological Control Effect on Rice Blast [J]. Biotechnology Bulletin, 2022, 38(6): 136-146. |
| [15] | WANG Chun-yan, LA Gui-xiao, SU Xiu-hong, LI Meng, DONG Cheng-ming. Screening of Endophytic Bacteria from Rehmannia glutinosa at Different Stages and Analysis of Their Growth-promoting Characteristics [J]. Biotechnology Bulletin, 2022, 38(4): 242-252. |
| Viewed | ||||||
|
Full text |
|
|||||
|
Abstract |
|
|||||